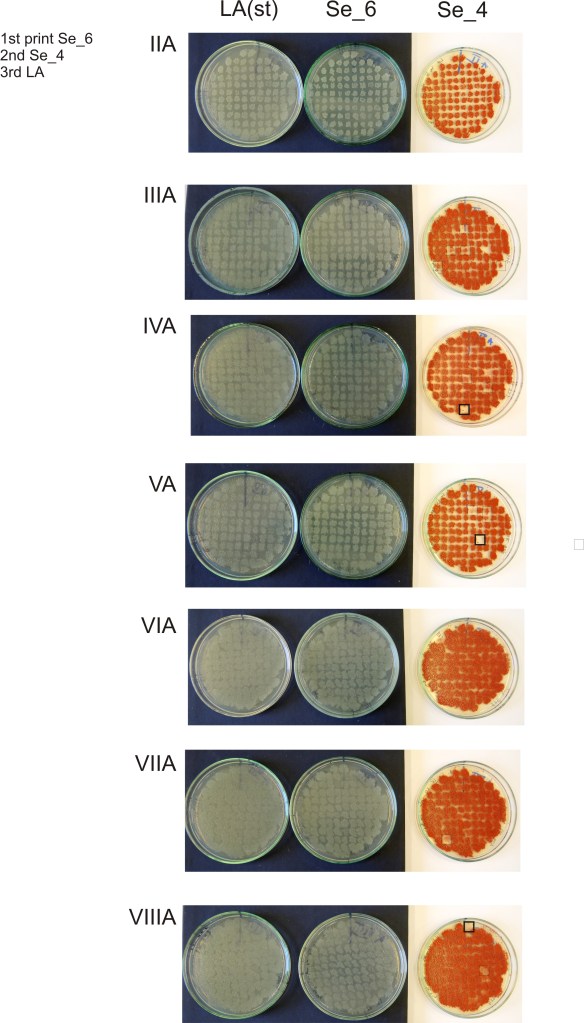

These two elements share numerous properties in common given their distribution in the periodic table. Both of them elicit toxic effects on bacterial metabolism. Of the two, only selenium serve an essential function, being present in two key aminoacids: selenocysteine and selenomethionine. Interestingly, both elements can also function as terminal electron acceptors in anaerobic respiration. Bacteria possessing enzyme systems capable to harvest energy from these transformations are believed to have thrived in the primeval past when the Earth’s atmosphere was devoid of oxygen. Today, in certain ecological “niches” and industrial settings (wastewaters, polluted soils) certain bacteria still rely heavily on arsenic and selenium. Among many, two prodigious scientists whose work on As and Se microbial respiration must be acknowledged are Ron Oremland (link) and John Stolz (link).
Our research related to As and Se metabolism covers several topics as follows:
- Co-respiration of the two elements in phylogenetically-diverse bacteria isolated from Mono Lake (California) and Zloty Stok (former gold mine in Sudetes Mountains, Poland).

Figure. Chemogenic (left) and biogenic orpiment (As2S3) produced by a strain of Shewanella.
2. Biomineralization of selenium in pure (Shewanella, Aeromonas, Bacillus etc) and mixed microbial communities (granular sludge samples from full-scale bioreactors).

Figure. Biogenic AsS and Se(-S)0 biominerals produced by a strain of Shewanella under anoxic conditions (figure credit: Federica Clincenaru https://meltlaboratory.com/)
3. Genetic determinants conferring resistance to selenium in Pseudomonas moraviensis stanleyae (link) investigated through transposon mutagenesis.
Figure. Pseudomonas mutants showing loss of resistance to selenium oxyanions (library created by transposon mutagenesis). Photo credit: prof. Dariusz Bartosik (University of Warsaw)
Publications
Staicu LC , Barton LL. (2021) “Selenium respiration in anaerobic bacteria: does energy generation pay off?” J Inorg Biochem 222, 111509 (read).
Acknowledgements
This project, “Co-respiration of arsenic and selenium in phylogenetically-diverse anaerobic bacteria: towards genetic, biochemical and evolutionary understanding”, is funded by National Science Center, Poland, grant number 2017/26/D/NZ1/00408.
